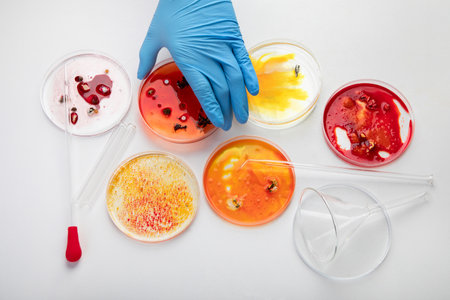
Background with laboratory petri dish. Microbiology science. Top view.の写真素材

写真素材 - Background with laboratory petri dish. Microbiology science. Top view.
作品情報
Background with laboratory petri dish. Microbiology science. Top view.
- ID:223581353
- 作品種別:写真
- 作者名:Tatjana Baibakova
キーワード
- analysis
- background
- bacterial
- bacteriology
- biochemistry
- biology
- biotechnology
- chemical
- clinic
- culture
- development
- discovery
- disease
- dish
- epidemic
- equipment
- experiment
- fungal
- genetic
- glasses
- growth
- health
- health care
- hygiene
- infection
- laboratory
- medical
- medicine
- microbe
- microbiology
- microorganism
- organism
- petri
- plate
- research
- safety
- sample
- science
- scientific
- study
- test
- treatment
- virus
類似作品
Male doctor wor...
chemist at blue...
Group of Petri ...
Close up of han...
Petri dish with...
Pink, blue and ...
Serum for skin ...
Scientist Works...
chemist wearing...
Glass medical a...
Petri dishes
Bacterial cultu...
Viruses and bac...
Researcher work...
Scientist Works...
Concept of scie...
Laboratory tech...
partial view of...
Laboratory glas...
Professional do...
covid-19 medici...
Demonstration o...
cosmetic cream ...
Microbiology ha...
Close-up of a s...
science and cli...
petri dish glas...
Close up the me...
Laboratory glas...
A small glass d...
Glass blurry ab...
Petri dishes wi...
Pipette with dr...
Antimicrobial s...
The male doctor...
Bacterial colon...
Pipetting colou...
Working table w...
Finding a cure....
Petri dishes wi...
Male doctor wor...
a doctor or res...
Microbiology la...
E. coli growing...
Dripping liquid...
scientist worki...
Research, exper...
Backgrounds of ...
Biotechnology